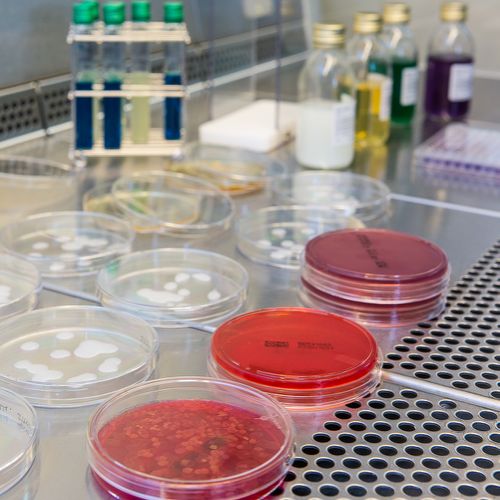
image
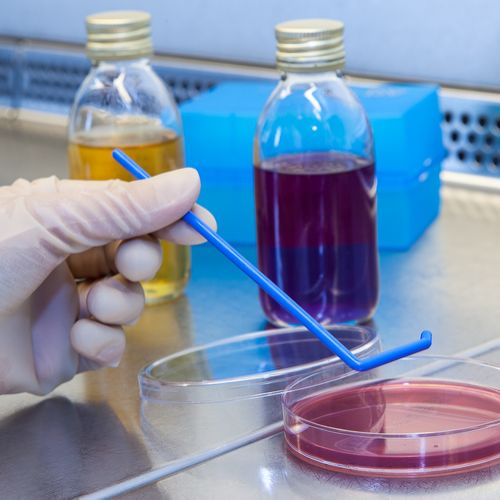

Laboratoires pharmaceutiques, chimistes, plasturgistes, imprimeurs, plasticiens, domaines viticoles, designers, créateurs, chambres de commerce et d'industrie, chambres des métiers ou de l'agriculture, industriels de l'alimentaire, acteurs dans le domaine du tourisme et de l'environnement et bien d'autres nous ont déjà fait confiance pour mettre en avant leur activité ou leur savoir-faire au travers de nos images.
Pourquoi pas votre entreprise ?
www.franckfouquet.eu / Copyright Tau Editions - Tous droits réservés - Mentions légales - CGU - Contact - Crédits photos : Franck FOUQUET - Les photos de ce site sont protégées par PixTrakk